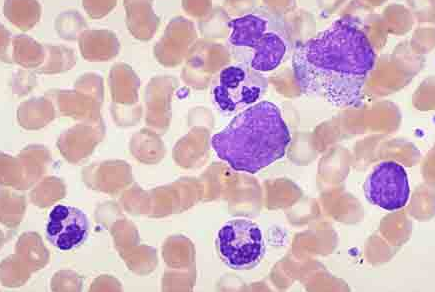

【资讯导读】该批准基于一项随机、多中心、开放标签对照试验(CLL14研究),该试验比较了威托克联合奥滨尤妥珠单抗(VEN G)和奥滨尤妥珠单抗联合苯丁酸氮芥治疗先前未治疗的CLL患者的疗效。共有43
该批准基于一项随机、多中心、开放标签对照试验(CLL14研究),该试验比较了威托克联合奥滨尤妥珠单抗(VEN G)和奥滨尤妥珠单抗联合苯丁酸氮芥治疗先前未治疗的CLL患者的疗效。共有432名先前未治疗的CLL临床症状患者被纳入研究。
这项研究的主要结果是由独立审查委员会评估的无进展生存率。与奥滨尤妥珠单抗联合苯丁酸氮芥治疗组相比,威托克联合奥滨尤妥珠单抗治疗组患者的PFS有统计学意义的改善。在中位随访28个月后,两组均未达到中位PFS。治疗组和对照组的总有效率分别为85%和71%,p=0.0007。此外,该研究还证实,患者骨髓和外周血中微小残留疾病的阴性率有统计学显著改善(每104个白细胞中少于1个CLL细胞)。总生存数据还不成熟。
在CLL/SLL患者中,当威托克与奥滨尤妥珠单抗、利妥昔单抗或威托克单药治疗联合使用时,最常见的不良反应(≥20%)包括中性粒细胞减少症、血小板减少症、贫血、腹泻、恶心、上呼吸道感染、咳嗽、肌肉骨骼疼痛、疲劳和水肿。
美国食品和药物管理局已经给予威托克优先认证,并授予“孤儿药”和“突破疗法”的称号。
威托克药品详细信息请进入:https://www.inmedf.com/zhongliu/bxb/20201624.html